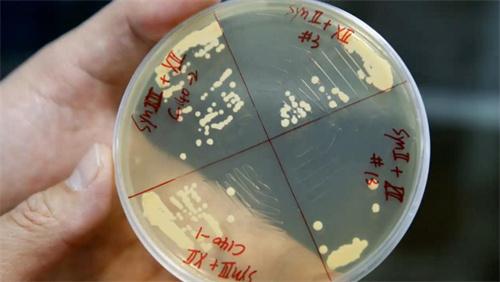

2016-2022 All Rights Reserved.平安財經網.復制必究 聯系QQ 備案號:
本站除標明“本站原創”外所有信息均轉載自互聯網 版權歸原作者所有。
郵箱:toplearningteam#gmail.com (請將#換成@)
11月16日,人民網發布文章報道,人工合成酵母基因組計劃研究人員近日在美國《細胞》雜志期刊中發表文章,他們在實驗室環境中制造出一中半天然半人工合成的酵母菌株。這種酵母菌株總共有7.5條人工合成的染色體,不僅成功存活而且還能夠像天然酵母菌株一樣進行復制生長。據了解,人工合成酵母基因組計劃是美國國家科學院院士杰夫伯克發起的一個項目,這一次的項目由中英美法等多個國家的研究院參與,也是人類歷史上首次嘗試合成真核生物。
根據相關資料介紹,該項目立項是為了重新設計并合成釀酒酵母的全部16條染色體。目前該項目的研究機構,已經把釀酒酵母的16個染色體全部合成成功,而且還創造出16種部分合成的酵母菌株。這些創造出來的酵母菌株當中,每一株都具有15條天然染色體和一條人工合成的染色體。

研究人員通過把這些中合酵母菌株進行雜交,在他們的下一代當中尋找具有兩條合成染色體的個體。不過在整合合成染色體的時候,該研究團隊還發現了一些問題,那就是這些合成酵母缺菌株是存在一遺傳缺陷,這些遺傳缺陷在只攜帶一條合成染色體的酵母菌株身上是看不見,后續研究團隊通過使用基因編輯的技術,修復了部分遺傳缺陷,并且對這些酵母菌株進行改善。

經過這些方式培育出來的下一代酵母菌株,再加入另外一條合成染色體,這樣就可以獲得一種擁有7.5條合成染色體的酵母菌株。這種酵母菌株燃已經具和天然酵母菌株同樣的復制和生存能力,很多研究人員對此指出,這個研究成果一旦能夠成功,便開啟了工程生物學的新時代。
2016-2022 All Rights Reserved.平安財經網.復制必究 聯系QQ 備案號:
本站除標明“本站原創”外所有信息均轉載自互聯網 版權歸原作者所有。
郵箱:toplearningteam#gmail.com (請將#換成@)